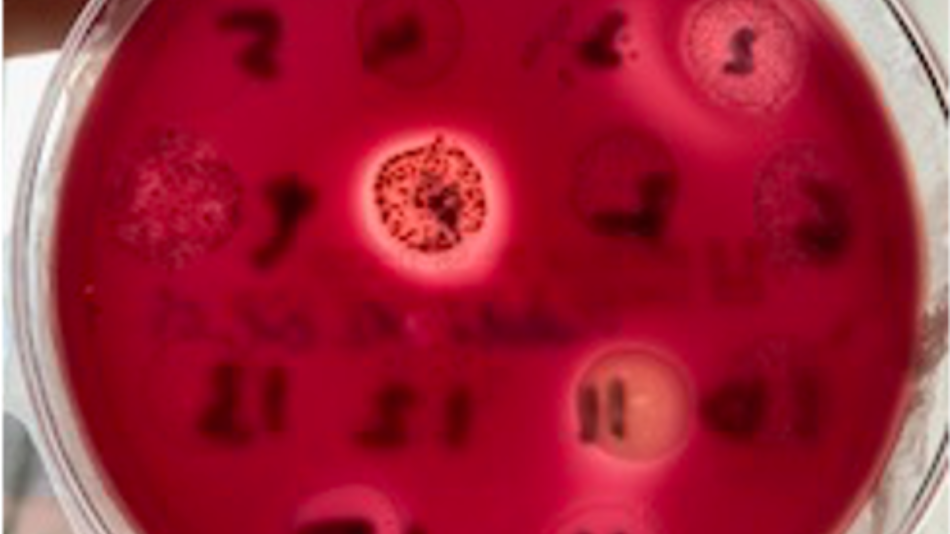
Mikrobiologie an der Universitätszahnklinik

Workshop
Mikrobiologie an der Universitätszahnklinik
Thema:
Gesundheit
Schlagworte:
Humanmedizin
Altersgruppe:
Alle
Zielgruppe:
Barrierefrei
Maximale Kapazität der Station: 5 Personen
© Universitätszahnklinik Wien
Besucherinformation
Anfahrtsbeschreibung: Straßenbahnlinien 5 und 33 Haltestelle: Lazarettgasse Straßenbahnlinien 43 und 44 Haltestelle: Lange Gasse Nächste LNF - Stationen: Sigmund Freud Statue - 4 Min Ignaz Semmelweis Statue - 4 Min Mitmachlabor Mikroskopie - 6 Min Gustav Klimt Fassade - 7 Min Zentrum für Translationale Medizin - 7 Min Zentrum für Immunologie - 8 min
Dieser Ausstellungsstandort ist barrierefrei zugänglich und verfügt über barrierefreie Toiletten.
MedUni Wien - Universitätszahnklinik Wien
Sensengasse 2a, 1090 Wien
Öffnungszeiten
Erster Einlass: 17:00
Letzter Einlass: 23:00
11 weitere Stationen an diesem Standort
-
 VortragAlles rund um den Zahn - KurzvorträgeThema: Digitalisierung GesundheitAlle 20 Minuten gibt es im Hörsaal an der Universitätszahnklinik einen spannenden Vortrag.Medizinische Forschungsmeile17:00 - 23:00
VortragAlles rund um den Zahn - KurzvorträgeThema: Digitalisierung GesundheitAlle 20 Minuten gibt es im Hörsaal an der Universitätszahnklinik einen spannenden Vortrag.Medizinische Forschungsmeile17:00 - 23:00 -
 AusstellungDigitale KieferorthopädieThema: Gesundheit NaturwissenschaftenAm Stand "Digitale Kieferorthopädie“ erkunden Besucher:innen jeden Alters interaktiv mit zwei Fachzahnärztinnen moderne Zahnkorrektur. Verschiedene Spangen – Metall-, Keramik- und linguale Brackets sowie transparente Aligner – können betrachtet und „begriffen“ werden. Alle Fragen sind willkommen, biomechanische Aspekte werden gemeinsam erforscht.Medizinische Forschungsmeile17:00 - 23:00
AusstellungDigitale KieferorthopädieThema: Gesundheit NaturwissenschaftenAm Stand "Digitale Kieferorthopädie“ erkunden Besucher:innen jeden Alters interaktiv mit zwei Fachzahnärztinnen moderne Zahnkorrektur. Verschiedene Spangen – Metall-, Keramik- und linguale Brackets sowie transparente Aligner – können betrachtet und „begriffen“ werden. Alle Fragen sind willkommen, biomechanische Aspekte werden gemeinsam erforscht.Medizinische Forschungsmeile17:00 - 23:00 -
 AusstellungKlinische Forschung für KiefergelenksdiagnostikThema: GesundheitBei dieser Station werden Axiographiegeräte (Geräte zur Erfassung und Analyse der Kiefergelenksbewegungen) ausgestellt.Medizinische Forschungsmeile17:00 - 23:00
AusstellungKlinische Forschung für KiefergelenksdiagnostikThema: GesundheitBei dieser Station werden Axiographiegeräte (Geräte zur Erfassung und Analyse der Kiefergelenksbewegungen) ausgestellt.Medizinische Forschungsmeile17:00 - 23:00 -
 MitmachstationLaser Anwendung in ZahnheilkundeThema: Naturwissenschaften TechnikZahnbehandlungen ohne Bohrgeräusche und ohne Vibrationen – das geht mit Lasertechnologie. Der Einsatz neuester Lasertechnologien ermöglicht viele innovative Behandlungsmethoden in der Zahnmedizin. Wie das funktioniert zeigen wir Ihnen am Modell mit dem Erbium Laser unter einem speziellen Schutzglas.Medizinische Forschungsmeile17:00 - 23:00
MitmachstationLaser Anwendung in ZahnheilkundeThema: Naturwissenschaften TechnikZahnbehandlungen ohne Bohrgeräusche und ohne Vibrationen – das geht mit Lasertechnologie. Der Einsatz neuester Lasertechnologien ermöglicht viele innovative Behandlungsmethoden in der Zahnmedizin. Wie das funktioniert zeigen wir Ihnen am Modell mit dem Erbium Laser unter einem speziellen Schutzglas.Medizinische Forschungsmeile17:00 - 23:00 -
 AusstellungMikroskopische Einblicke in histologische SchnitteThema: Gesundheit NaturwissenschaftenDurch das Mikroskop gewinnt man Einblicke in histologische Schnitte, um unterschiedliche Gewebearten erkennen und beschreiben zu können. Durch unterschiedliche Färbemethoden kann man z.B. Nachweise verschiedenster Proteine erzielen.Medizinische Forschungsmeile17:00 - 23:00
AusstellungMikroskopische Einblicke in histologische SchnitteThema: Gesundheit NaturwissenschaftenDurch das Mikroskop gewinnt man Einblicke in histologische Schnitte, um unterschiedliche Gewebearten erkennen und beschreiben zu können. Durch unterschiedliche Färbemethoden kann man z.B. Nachweise verschiedenster Proteine erzielen.Medizinische Forschungsmeile17:00 - 23:00 -
 AusstellungStarke Zähne für starke Kinder - von Anfang an, ein Leben langThema: GesundheitKinder zählen zu den sensibelsten Patient:innen in der Zahn-, Mund- und Kieferheilkunde. Ihre Behandlung erfordert großes Einfühlungsvermögen, viel Ruhe und einen langfristigen Vertrauensaufbau. So kann eine solide Basis für die Gesundheit der Zähne von Kindern geschaffen werden. Informationen zu Zahnputztechniken im Kindesalter, Fluoridnutzung und zahngesunder Ernährung.Medizinische Forschungsmeile17:00 - 23:00
AusstellungStarke Zähne für starke Kinder - von Anfang an, ein Leben langThema: GesundheitKinder zählen zu den sensibelsten Patient:innen in der Zahn-, Mund- und Kieferheilkunde. Ihre Behandlung erfordert großes Einfühlungsvermögen, viel Ruhe und einen langfristigen Vertrauensaufbau. So kann eine solide Basis für die Gesundheit der Zähne von Kindern geschaffen werden. Informationen zu Zahnputztechniken im Kindesalter, Fluoridnutzung und zahngesunder Ernährung.Medizinische Forschungsmeile17:00 - 23:00 -
 MitmachstationVisualisierung von Stammzellen auf ZahnimplantatenThema: GesundheitIn unserer Forschungsstation können Sie unsere Arbeit zur Wechselwirkung zwischen Zahnimplantaten und verschiedenen Zahngeweben erleben. Wir kultivieren Stammzellen auf unterschiedlichen Implantatoberflächen und visualisieren sie anschließend mit speziell entwickelten Fluoreszenzfarbstoffen. Sie können diese Zellen mit einem modernen Fluoreszenzmikroskop beobachten, das wir täglich in unserer Forschung einsetzen.Medizinische Forschungsmeile17:00 - 23:00
MitmachstationVisualisierung von Stammzellen auf ZahnimplantatenThema: GesundheitIn unserer Forschungsstation können Sie unsere Arbeit zur Wechselwirkung zwischen Zahnimplantaten und verschiedenen Zahngeweben erleben. Wir kultivieren Stammzellen auf unterschiedlichen Implantatoberflächen und visualisieren sie anschließend mit speziell entwickelten Fluoreszenzfarbstoffen. Sie können diese Zellen mit einem modernen Fluoreszenzmikroskop beobachten, das wir täglich in unserer Forschung einsetzen.Medizinische Forschungsmeile17:00 - 23:00 -
 MitmachstationZahnschmerzen – was tun? Arbeiten Sie wie Zahnärzt:innen!Thema: GesundheitAn dieser Station können Sie selbstständig zahnfarbene Füllungen anfertigen. Außerdem erfahren Sie Details über die Wissenschaft von Füllungen und deren Lichthärtung!Medizinische Forschungsmeile17:00 - 23:00
MitmachstationZahnschmerzen – was tun? Arbeiten Sie wie Zahnärzt:innen!Thema: GesundheitAn dieser Station können Sie selbstständig zahnfarbene Füllungen anfertigen. Außerdem erfahren Sie Details über die Wissenschaft von Füllungen und deren Lichthärtung!Medizinische Forschungsmeile17:00 - 23:00 -
 MitmachstationZähne & Implantate ganz nahThema: Gesundheit NaturwissenschaftenWie untersucht man Zähne, Knochen und Implantate mikroskopisch – und wie funktionieren Implantate eigentlich? Tauchen Sie ein in die Welt der Mikroskopie und entdecken Sie, wie Implantate im Knochen einwachsen, warum manche Materialien besser geeignet sind und welche faszinierenden Details erst unter starker Vergrößerung sichtbar werden.Medizinische Forschungsmeile17:00 - 23:00
MitmachstationZähne & Implantate ganz nahThema: Gesundheit NaturwissenschaftenWie untersucht man Zähne, Knochen und Implantate mikroskopisch – und wie funktionieren Implantate eigentlich? Tauchen Sie ein in die Welt der Mikroskopie und entdecken Sie, wie Implantate im Knochen einwachsen, warum manche Materialien besser geeignet sind und welche faszinierenden Details erst unter starker Vergrößerung sichtbar werden.Medizinische Forschungsmeile17:00 - 23:00 -
 MitmachstationZähne als Spiegel der VergangenheitThema: Gesundheit NaturwissenschaftenKrankheiten wie Karies sind stark von der Ernährung und Lebensweise abhängig. Seit der Zeit der Jäger und Sammler, über frühe Ackerbauern bis hin zu den Menschen des Barock haben sich die Lebensgewohnheiten stark verändert. Anhand von archäologischen Schädeln können Besucher in einer Hands-on Demonstration die Veränderungen an den Gebissen selbst beobachten.Medizinische Forschungsmeile17:00 - 23:00
MitmachstationZähne als Spiegel der VergangenheitThema: Gesundheit NaturwissenschaftenKrankheiten wie Karies sind stark von der Ernährung und Lebensweise abhängig. Seit der Zeit der Jäger und Sammler, über frühe Ackerbauern bis hin zu den Menschen des Barock haben sich die Lebensgewohnheiten stark verändert. Anhand von archäologischen Schädeln können Besucher in einer Hands-on Demonstration die Veränderungen an den Gebissen selbst beobachten.Medizinische Forschungsmeile17:00 - 23:00 -
 MitmachstationiTop ZähneputzenThema: GesundheitWie putzt man Zähne wirklich richtig? An unserer Zähneputzstation erhalten Besucher:innen persönliche Tipps von Expert:innen. Schritt für Schritt zeigen wir einfache Putztechniken, den richtigen Druck und gute Bewegungen für gesunde Zähne und gesundes Zahnfleisch. Mitmachen, ausprobieren und praktische Alltagstipps mitnehmen!Medizinische Forschungsmeile17:00 - 23:00
MitmachstationiTop ZähneputzenThema: GesundheitWie putzt man Zähne wirklich richtig? An unserer Zähneputzstation erhalten Besucher:innen persönliche Tipps von Expert:innen. Schritt für Schritt zeigen wir einfache Putztechniken, den richtigen Druck und gute Bewegungen für gesunde Zähne und gesundes Zahnfleisch. Mitmachen, ausprobieren und praktische Alltagstipps mitnehmen!Medizinische Forschungsmeile17:00 - 23:00






